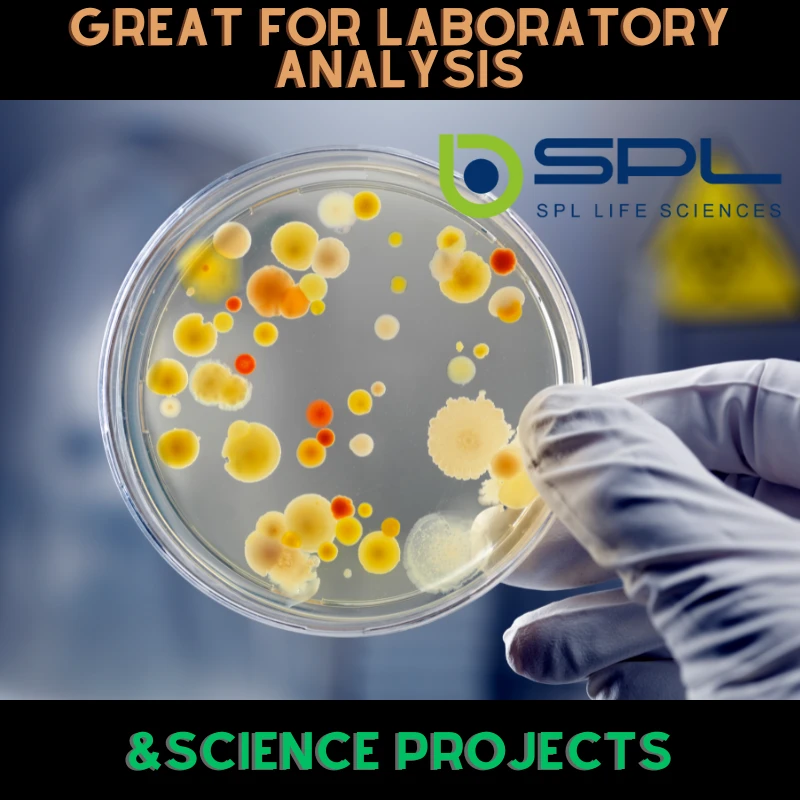
SPL Cell Culture Dish, 90 x 20 mm, Treated, Vented Lid, Sterile

DISH// 生写真 17076459_251471431977601_10442
(3044件)
Pontaパス特典
サンキュー配送
27500円(税込)
275ポイント(1%)
Pontaパス会員ならさらに+1%ポイント還元!
送料
(
)
3042
配送情報
お届け予定日:2026.04.11 9:57までにお届け
※一部地域・離島につきましては、表示のお届け予定日期間内にお届けできない場合があります。
ロットナンバー
24676115220
お買い物の前にチェック!

Pontaパス会員なら
ポイント+1%
ポイント+1%
商品説明
















『皿 vs オールスラ マジで俺たち野音やるの!? こうなったらスラッシャー全員強制集合!!』1セット ¥1500『皿組キャンプ2014夏 in 東西2大野音』1セット ¥1500『DISH// 日本武道館単独公演 '15 元日 ~尖った夢の先へ~』1セット ¥1300『皿vsスラ“世界サラ一級タイトルマッチ”~2015年 春編~』1セット ¥1300⭐︎以下追加(画像5枚目以降)『DISH//3rdシングルリリース記念バンドルライブ 皿 vs スラ”世界サラー級タイトルマッチ”~2014 冬→春編~』『EBiDAN THE LIVE ~飛び出すEBi本 2014 Summer Party~』『サンタも皿もBIGり!!2周年記念パーリナイッ☆@Zepp Tokyo』※画像7.8.9枚目グッズ詳細不明ですが、・DISH//セット・柊生以外のソロセットだったと思います。『DISH// 2014 Spring ホールツアー『D//PINK』』※画像10〜16枚目こちらもグッズ詳細不明なのですが、青背景・ピンク背景それぞれ、・DISH//セット・ソロセットだったと思います。質問等ございましたらコメント下さい。
| カテゴリー: | ゲーム・おもちゃ・グッズ>>>タレントグッズ>>>ミュージシャン |
|---|---|
| 商品の状態: | 目立った傷や汚れなし","細かな使用感・傷・汚れはあるが、目立たない |
| 配送料の負担: | 送料込み(出品者負担) |
| 配送の方法: | 未定 |
| 発送元の地域: | 埼玉県 |
| 発送までの日数: | 4~7日で発送 |
レビュー
商品の評価:




 4.3点(3044件)
4.3点(3044件)
- しばりん11さい
- 今までノコギリが必要だった太さの枝がこのハサミで切れるようになりました。庭仕事の効率がアップして助かります。ちょっと重いけど…
- かねてつ5401
- "頼んで左利き用に作って頂きました。 電話連絡で緊密に連絡が出来、思い通りに出来上がりました。 左利きですが、いつもは、右利き用を使っていたストレスがなくなり、スパスパと作業が進みます。 そして、さすが、伝統があり 切れ味抜群です。 本来の右利き用は6
- ヒロトモキ
- めっちゃよく切れます。ストレスなくお庭の手入れができました!
- あややん8028
- 庭の手入れに75歳の父に頼まれて購入しました ナイロンのベルトが付属されてて、その取り付けがわからないと言いながら、付けずに伸びた枝を切ってました 年寄りにも簡単に設置や作業が出来るようで満足です
- basibashi
- 通常価格よりお安く2880円でした。さらに5%引きです。土と同梱してもらえるので送料がかからず助かりました。専用の剪定ばさみを持っておらず良く切れる万能鋏で代用してましたが、ちょうどいい機会に購入できてよかったです。
- ウォーリーさん
- 素晴らしい切れ味です。かなりビックリしました。細い枝は勿論ですが無理かもと思う太めの枝も刃の根元部分の太枝切り部分でガシガシ切れました。流石日本製です。大事に長く使っていきたいと思います。
- ナスビ5289
- 軽いし、シンプルな外見も気に入りました。するっと切れます。
- ゆうちん330
- 届いてさっそく使ってみました。握りが今まで使っていた物より一回り小さく、手になじみます。刃先が細いので混み合った枝の間でも切りたい枝以外を傷つけずにねらえます。もちろん切れ味もよく、ちょっとお試しのつもりだったのに、雨が降ってこなかったら止まらなくなるところでしたw これから大いに役立ってくれそうです。 [受注番号]305721-20150616-0797978112 *今までは使い続けると親指に疲れがきたのですが、それが大幅に軽減されそうです。手の小さい私にはちょうどいいサイズです。
- sukoburu
- 太い枝は切りにくいし限度がありますが(おそらくそういうことだろうと分かっていての注文です^^)細い枝は切りやすいし多少切り切れて無くてもパキッとはさみを曲げれば切り取れてそのまま挟んで手元に下ろせるので女性の私でも重くないし使いやすいです(^−^) 脚立に乗ることを考えたら(怖いですし、面倒ですし)手軽で便利です。
すべて見る
お店の情報
7,367
連絡・応対
4.3
配送スピード
4.3
梱包
4.3